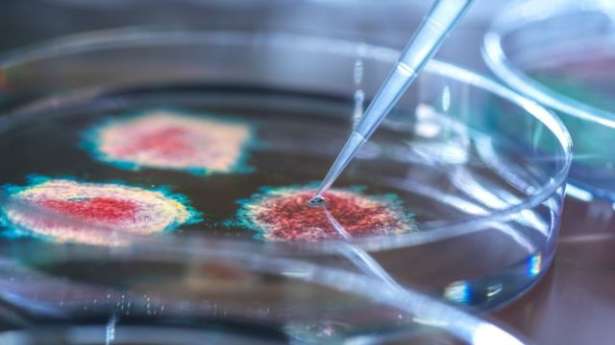

அமெரிக்காவில் புதிய வகை கொவிட் தொற்று பரவும் அபாயம்...
20 மார்கழி 2023 புதன் 08:20 | பார்வைகள் : 8987
அமெரிக்க மாநிலங்களில் HV.1 எனப்படும் புதிய கொவிட் மாறுபாடு பரவி வருவதாக தகவல் வெளியாகியுள்ளது.
இது மிகவும் தொற்றக்கூடிய ஓமிக்ரான் துணை வகையாகும்.
நோய் கட்டுப்பாடு மற்றும் தடுப்புக்கான அமெரிக்க மையங்களின்படி இது ஒக்டோபரில் EG.5 உள்ளிட்ட பிற கொவிட் வகைகளை விரைவாக முந்தியது.
டிசம்பரில், இது அமெரிக்க குடிமக்களிடையே புதிய COVID-19 நோய்த்தொற்றுகளில் 30 சதவீதம் ஆகும்.
நவம்பர் 2021 இல் அமெரிக்காவில் ஓமிக்ரான் பரவத் தொடங்கியது.
CDC இன் SARS-CoV-2 வரிசை மரத்தின் படி, HV.1 என்பது ஓமிக்ரான் XBB.1.9.2 இன் துணை வரிசை மற்றும் EG.5 இன் நேரடி வழித்தோன்றலாகும்.
மற்ற கொவிட் வகைகளைப் போலவே, புதிய எச்.வி.1 வைரஸும் மிகவும் தொற்றக்கூடியது.
அடிக்கடி ஏற்படும் பிறழ்வுகள் புதிய மாறுபாடுகளை வேகமாகப் பரவச் செய்கின்றன என்று CDC மேலும் கூறியது.
7 நாள்கள் முன்னர்
மரண அறிவித்தல்

மேரி பிறக்சிற்றம்மா
புதுக்கோட்டை (இந்தியா), யாழ்/நெடுந்தீவு
வயது : 80
இறப்பு : 26 Sep 2025
-
1